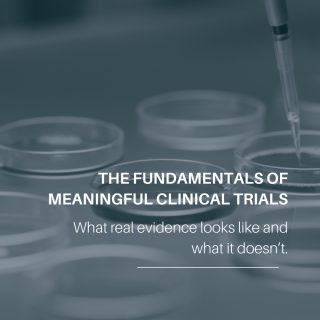
Not all “science-backed” claims are built on the same foundation.
And not all studies deserve equal confidence.
The credibility of a claim depends on how the study was designed—not how compelling the headline sounds. Study structure, bias control, sample size, statistical power, endpoints, and reproducibility determine whether a finding reflects real biological effect or preliminary observation.
Randomized, double-blind, placebo-controlled trials are designed to test causality.
Observational data, case reports, and in-vitro studies are designed to explore possibilities.
In beauty, wellness, and longevity, exploratory data is often presented as proof. Knowing where a study sits on the evidence hierarchy helps separate what’s validated, what’s suggestive, and what’s purely promotional.
Good science isn’t about collecting studies.
It’s about trusting the right ones.

The Best Treatment
Timeless Spirit
Kind to Skin.
Choose your
Skincare Match
Find your skincare routine from our luxurious collection! Discover the ideal blend for your skincare needs, be it moisturizer, age defense, or cleansing treatment. With our variety of items, attain glowing and wholesome skin each day.
-
BIO SOLUTIONS
€ 76.00
Bakuchiol Phyto-Retinol Concentrate -
INTENSILUX®
€ 130.00
Intensive Therapy Eye Cream -
BIO SOLUTIONS
€ 75.00
Supreme Body Therapy Lotion -
BIO SOLUTIONS
€ 25.00
Diamond Lip Plump Treatment -
BIO SOLUTIONS
€ 30.00
10 % AHA – 2 % BHA Gel -
THERMAOX®
€ 58.00
Mineral•Vitamin•Antioxidant Enriched Clay Detox Mask with Spirulina -
BIO SOLUTIONS
€ 89.00
Hydro Filler Boost Concentrate -
INTENSILUX®
€ 48.00
Intensive Therapy Cleansing Gel
New Collections
Featured Products
- All Products
- BIO SOLUTIONS
- INTENSILUX®
- MULTIPEPTIDEX®
- THERMAOX®
-
THERMAOX®
€ 74.00
Mineral•Vitamin•Antioxidant Enriched Moisturizer -
THERMAOX®
€ 56.00
Mineral•Vitamin•Antioxidant Enriched Eye Cream -
THERMAOX®
€ 63.00
Mineral•Vitamin•Antioxidant Enriched Serum -
THERMAOX®
€ 26.00
Mineral•Vitamin•Antioxidant enriched cleansing gel -
MULTIPEPTIDEX®
€ 121.00
Antiwrinkle Peptide Enriched Moisturizer
SCIENCE
We are committed to leading the skincare industry in terms of research innovation and we promise to provide advanced, organic skincare supported by science. All formulations are researched and developed by ASYA GRAFY BIO Institute scientists.
NATURE
Europe is well known for its diversity and blooming nature, where powerful ingredients are waiting for their discovery. We are collaborating with the best biotechnology labs all over Europe to find the most secret and powerful cutting edge, active ingredients.
” A healthy youthful skin is not a destination, it’s a journey of discovery.”
– Dr Asya Grafy

for children with Learing problems or disabilities.
social Feed
Are you following us on Instagram?




















Subscribe to our newsletter